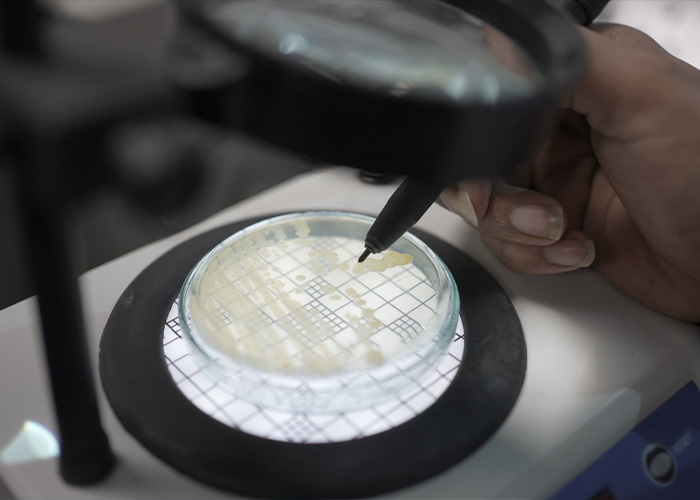

Quality Control Laboratory
Endoc Lifecare has established a modern, fully equipped
Quality Control Laboratory, staffed by highly qualified and
experienced scientists. Our QA/QC block is designed to perform comprehensive testing at every stage—intermediate, in-process,
and final product analysis.

Quality Control Laboratory
Endoc Lifecare has established a modern, fully equipped Quality Control Laboratory, staffed by highly qualified and experienced scientists. Our QA/QC block is designed to perform comprehensive testing at every stage—intermediate, in-process, and final product analysis.

Laboratory Blocks and Facilities
- Wet Chemistry Lab for routine analysis
- Common Instrumentation Lab housing shared analytical tools
- Dedicated HPLC and GC
- Stability Suite with three-zone chambers and a photostability cabinet
- Chemical Storage and Retained Sample Rooms
- Separate Microbiology Lab for sterility testing and microbial limit assays


Laboratory Blocks and Facilities
- Wet Chemistry Lab for routine analysis
- Common Instrumentation Lab housing shared analytical tools
- Dedicated HPLC and GC
- Stability Suite with three-zone chambers and a photostability cabinet
- Chemical Storage and Retained Sample Rooms
- Separate Microbiology Lab for sterility testing and microbial limit assays

Key Instrumentation
- HPLC systems equipped with IR, UV and DAD detectors
- FTIR interface and GC units with headspace sampling
- Osmometer and Karl Fisher
- Mercury-droplet Voltammetry Apparatus
- Auto titrators for precise endpoint determination
- Spectrophotometers and pH meters

Key Instrumentation
- HPLC systems equipped with IR, UV and DAD detectors
- FTIR interface and GC units with headspace sampling
- Osmometer and Karl Fisher
- Mercury-droplet Voltammetry Apparatus
- Auto titrators for precise endpoint determination
- Spectrophotometers and pH meters
Stability Testing
Our in-house stability program includes:
-
Long-term, intermediate, and accelerated studies in
climate-controlled chambers - Photostability testing per ICH guidelines
- Digital data capture and real-time monitoring


Stability Testing
Our in-house stability program includes:
-
Long-term, intermediate, and accelerated studies in
climate-controlled chambers - Photostability testing per ICH guidelines
- Digital data capture and real-time monitoring

Microbiology Capabilities
The Microbiology Lab features:
- Air samplers and clean-room validation equipment
- BOD incubators and autoclaves
- Facilities to perform all microbial limit tests (MLT) and separate culture transfer room
Microbiology Capabilities
The Microbiology Lab features:
- Air samplers and clean-room validation equipment
- BOD incubators and autoclaves
- Facilities to perform all microbial limit tests (MLT) and separate culture transfer room
Quality Assurance & Regulatory Affairs
Our QA and Regulatory Affairs team follows ICH guidelines and oversees:
- cGMP implementation and validation protocols
- Internal and external audits, compliance monitoring, and CAPA
- DMF preparation, submission, and regulatory updates for both emerging and regulated markets
This integrated QA/QC framework ensures every batch leaving Endoc Lifecare meets the highest global standards of safety, purity, and consistency.


Quality Assurance & Regulatory Affairs
Our QA and Regulatory Affairs team follows ICH guidelines and oversees:
- cGMP implementation and validation protocols
- Internal and external audits, compliance monitoring, and CAPA
- DMF preparation, submission, and regulatory updates for both emerging and regulated markets
This integrated QA/QC framework ensures every batch leaving Endoc Lifecare meets the highest global standards of safety, purity, and consistency.

